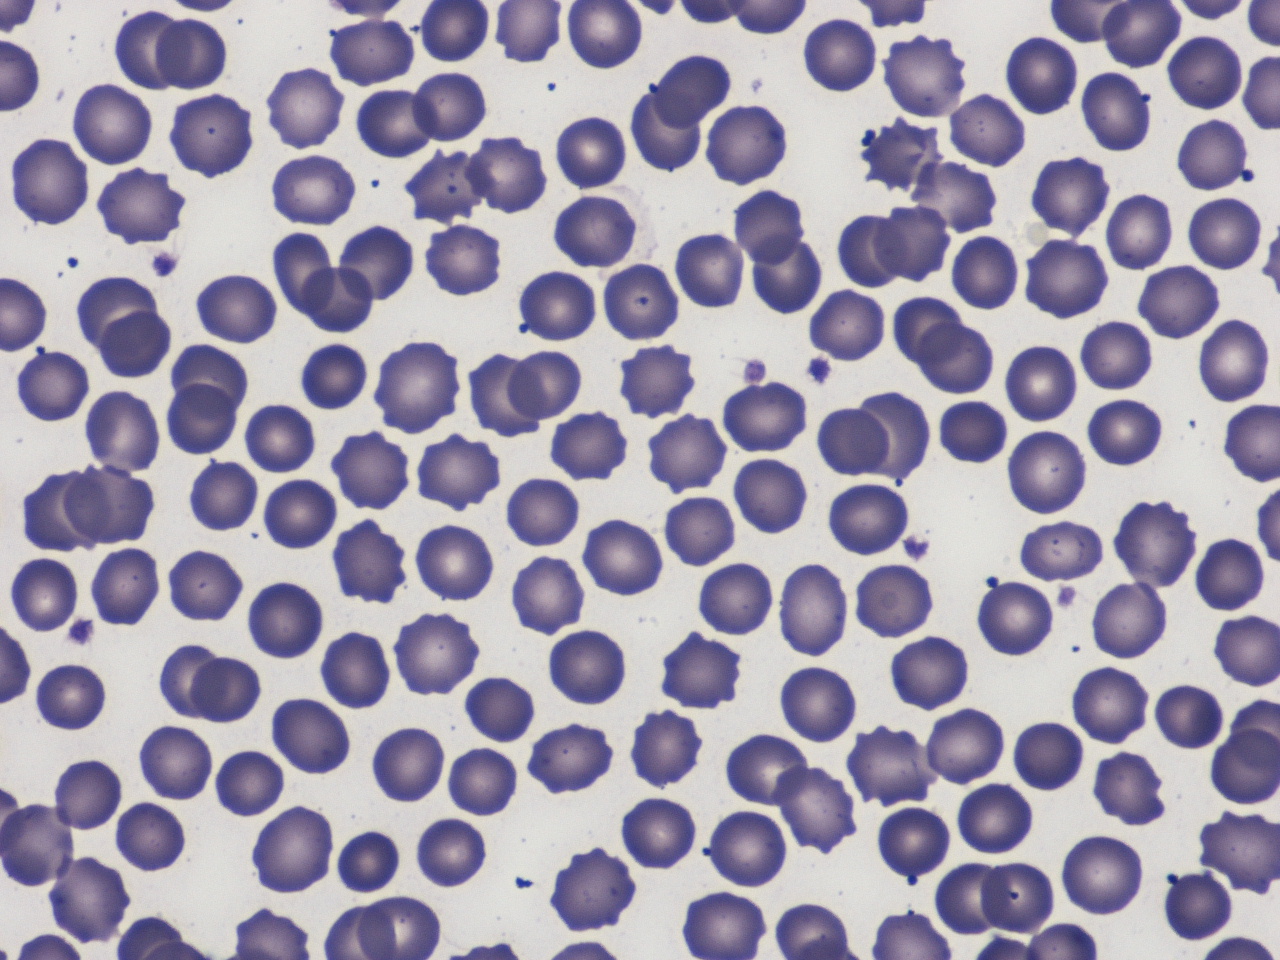

Incremento delle transaminasi in un bambino con ipofibrinogenemia congenita e ipobetalipoproteinemia famigliare
1U.O. Pediatria, Ospedale G.B. Morgagni - L. Pierantoni, AUSL di Forl�
2Dottorato in Imaging Multimodale in Biomedicina, Universit� di Verona, Verona
Indirizzo per la corrispondenza: e.valletta@ausl.fo.it
Abnormal transaminases in a child with congenital hypofibrinogenemia and familial hypobetalipoproteinemia
Key
words
Transaminases, Hypocholesterolemia, Hypofibrinogenemia, Hypobetalipoproteinemia, Apolipoprotein B
Abstract
The article reports the case of a 32-month child, born at the 28th week of gestational age, with a slight persistent increase in AST and ALT since the 11th month of age, hypofibrinogenemia and initial growth delay. Investigations excluded common causes of transaminase alteration and showed severe hypocholesterolemia and hypotrigliceridemia and absence of apoB 100, LDL and VLDL. Biochemical findings were consistent with familial hypobetalipoproteinemia, even if known mutations of MTP and APOB genes were not found. Low fibrinogen levels were due to a rare heterozygous mutation of the FGG gene (fibrinogen Aguadilla) that is probably responsible for hepatocellular damage. The diagnostic approach to the child with abnormal transaminases was briefly summarized and two rare diseases and their possible pathogenetic linkage were reviewed.
Riassunto
Descriviamo il caso di un bambino di 32 mesi, ex-prematuro, che dagli 11 mesi di et� mostra un persistente, moderato incremento di AST e ALT, un'ipofibrinogenemia e una lieve flessione della curva di crescita. Gli accertamenti consentono di escludere le pi� comuni cause di ipertransaminasemia mentre emerge un'importante ipocolesterolemia con ipotrigliceridemia, apolipoproteina B100 indosabile e assenza pressoch� completa di LDL e VLDL. Il fenotipo � quello della abetalipoproteinemia ma gli accertamenti sui genitori indirizzano piuttosto verso una ipobetalipoproteinemia famigliare. Le indagini genetiche sul gene MTP e sul gene APOB sono risultate, tuttavia, negative. Il difetto di fibrinogeno �, invece, espressione di una rara mutazione eterozigote del gene FGG (fibrinogeno Aguadilla) verosimilmente responsabile del danno epatocitario. Questo caso, partendo dall'approccio al bambino con ipertransaminasemia ci consente di richiamare alla memoria due patologie rare e discuterne gli aspetti patogenetici di possibile correlazione.
Introduzione
L'incremento delle transaminasi (AST e/o ALT) in un bambino apparentemente in buona salute � evento non raro che impone di escludere un piccolo numero di patologie significative1. E' per lo pi� espressione di un danno dell'epatocita (anche solo di alterata permeabilit� della membrana cellulare) anche se l'AST � ben rappresentata nel cuore, muscolo scheletrico, rene, cervello ed eritrociti e l'ALT �, in minor misura, rinvenibile nel muscolo scheletrico e nel rene. Pur escludendo le epatopatie acute con elevazione importante (>10x) degli enzimi � spesso con incremento degli indici di colestasi (ALP, GGT e bilirubina) � secondarie a grave insulto tossico, ischemico o virale, anche i modesti ma persistenti movimenti delle transaminasi meritano attenzione1,2. I problemi possono essere diversi; alcuni pi� comuni (virus dell'epatite, CMV, EBV, rotavirus, steatosi epatica del bambino obeso, celiachia), altri meno frequenti ma clinicamente rilevanti (epatite autoimmune, deficit di alfa-1 antitripsina, malattia di Wilson, fibrosi cistica, distrofia muscolare). O ancora pi� inattesi, come nel caso che qui descriviamo.
Caso clinico
D. nasce primogenito (dopo una prima gravidanza abortita spontaneamente a 6 settimane) a 28 settimane per grave gestosi. Il peso � 860 g, ma dopo un breve periodo di ventilazione meccanica viene dimesso senza ulteriori problemi con un peso di 1990 g. Nei mesi successivi non ci sono eventi di rilievo, allattamento misto con svezzamento regolare, discreta tendenza al recupero ponderale e sviluppo psicomotorio compatibile con la sua grave prematurit�. Durante i controlli di routine, a 11 mesi di et�, emerge un modesto incremento di AST (65 U/L) e ALT (84 U/L) in apparente benessere che, per il momento, non desta preoccupazione. A due anni di vita, gli esami fatti per un iniziale rallentamento della curva di crescita (Figura 1) ripropongono l'ipertransaminasemia (AST 135 U/L, ALT 196 U/L) in assenza di colestasi. La sierologia per epatite A-B-C, EBV, CMV e celiachia � negativa, alfa-1 antitripsina, rame e ceruloplasmina sono nei limiti di norma. A sorpresa emerge un'ipofibrinogenemia (65 mg/dl) e un modesto allungamento del PT in assenza di qualsiasi episodio anamnestico di prolungato sanguinamento. Siamo ormai a 32 mesi di et� e, d'accordo con la Pediatra, decidiamo di ricoverare il bambino.
D. ha l'aspetto comune a molti bambini che hanno avuto un inizio difficile: un po' piccolo (87 cm, 2� cent.), un po' magro (11.3 kg, 5� cent.), ma in buone condizioni, vivace, collaborante, non parla molto, ma si fa capire bene a gesti. L'obiettivit� generale � priva di elementi di rilievo ed il fegato � poco oltre l'arcata costale. Completiamo la lista delle ipotesi ancora da esplorare (fibrosi cistica, malattie metaboliche, autoimmunit�, funzione e sintesi epatica, funzione tiroidea, enzimi muscolari), ma gi� gli esami di routine ci danno un'indicazione importante. Colesterolo (27 mg/dl; v.n. <200) e trigliceridi (13 mg/dl; v.n. <150) sono molto bassi, le transaminasi sono come al consueto (AST 146 U/L, ALT 184 U/L) senza segni di colestasi e con funzione epatica conservata, si confermano l'ipofibrinogenemia (67 mg/dl (v.n. 150-400)) e la lieve alterazione coagulativa (PT-INR 1,56 (0,83-1,11), APTT 0,95 (0,85-1,17)) non responsiva alla vit. K. L'alvo � regolare, chimotripsina ed elastasi fecali sono normali, non c'� steatorrea, il test del sudore � negativo, vit. A e D sono normali e la vit. E (0,29 mg/dl (0,31-0,90)) � di poco inferiore ai limiti di norma. L'ecografia epatica non mostra segni di steatosi. Le situazioni nelle quali colesterolo e trigliceridi possono essere cos� bassi sono poche e il capitolo dell'abetalipoproteinemia (ABL) ben si adatta al nostro caso. Il dosaggio delle apolipoproteine conferma l'ipotesi: apo A1 � a 0,64 g/l (>1), apo B100 � a concentrazioni indosabili (0,6-1,4 g/l) e il lipidogramma mostra la totale assenza delle LDL e delle VLDL e una sensibile riduzione delle HDL. Interessante, perch� verosimilmente testimone di una residua attivit� dell'Apo B48, la comparsa di una banda chilomicronica e di un siero lipemico in uno dei due campioni testati. Cerchiamo l'acantocitosi nello striscio di sangue periferico e, ulteriore conferma, la troviamo (Figura 2). Non resta che testare i genitori per chiarire se siamo di fronte ad una ABL classica (autosomica recessiva) o ad una ipobetalipoproteinemia famigliare (IBLF) in forma omozigote. Le alterazioni dell'assetto lipidico che emergono fanno propendere per la seconda ipotesi (Tabella I) con una situazione di parziale difetto dell'apoB 100 in entrambi i genitori. L'ipotesi di una ipofibrinogenemia congenita sembra trovare conferma in una ridotta concentrazione di fibrinogeno nel prelievo paterno (135 mg/dl) (Tabella I). Nella storia neonatale del bambino recuperiamo soltanto una ipofibrinogenemia (49 mg/dl) gi� allora presente, con transaminasi sostanzialmente normali.
Alcuni dati ematochimici relativi al bambino e ai genitori | ||||||
Colesterolo (mg/dl) |
Trigliceridi (mg/dl) |
ApoB 100 (g/L) (vn 0.6-1.4) |
ApoA 1 (g/L) (vn >1) |
Fibrinogeno (mg/dl) (vn 150-400) |
PT/APTT | |
Probando |
27 |
13 |
indosabile |
0.6 |
67 |
↑ / N |
Padre |
137 |
67 |
0.66 |
1.36 |
135 |
N/N |
Madre |
150 |
48 |
0.66 |
1.43 |
369 |
N/N |
Tabella I.
Concludiamo, quindi, per una IBLF associata a un ipofibrinogenemia congenita eterozigote. Visita oculistica e fundus, RNM encefalo, EEG, elettromiografia e potenziali motori e somatosensitivi escludono, al momento le principali complicanze dell'abetalipoproteinemia. Dopo infusione di fibrinogeno concentrato vengono prelevate, in endoscopia, biopsie duodenali che non evidenziano significativo accumulo di lipidi negli enterociti sia alla microscopia tradizionale che a quella elettronica. Decidiamo di integrare l'apporto di vit. E per os monitorando i livelli delle vitamine liposolubili e forniamo una piccola quota di grassi MCT con la dieta.
Dal punto di vista genetico, viene esclusa un�abetalipoproteinemia per l'assenza di mutazioni patogenetiche a carico del gene codificante la proteina microsomiale di trasferimento dei trigliceridi (MTP), ma anche il sequenziamento completo del gene APOB non evidenzia mutazioni significative per IBLF. L'ipofibrinogenemia risulta, invece, secondaria ad una mutazione (γ375 Arg→Trp) del gene FGG che sintetizza per la catena gamma del fibrinogeno e che produce una proteina strutturalmente modificata (fibrinogeno Aguadilla) e potenzialmente epatolesiva per accumulo nel reticolo endoplasmatico degli epatociti.
Oggi D. ha 5 anni, ha un lieve ritardo psicomotorio globale, pesa 15 kg ed � alto 105 cm con un andamento regolare poco sopra il 3� centile (Figura 1). Il colesterolo � 63 mg/dl, trigliceridi 24 mg/dl, AST 127 U/L e ALT 130 U/L, normali concentrazioni di vit. A, D ed E. Il fibrinogeno � 66 mg/dl e non si sono mai verificati episodi emorragici. All'ecografia il fegato mantiene ancora un'ecostruttura omogenea senza apprezzabile steatosi.
Figura 1. Andamento delle curve di crescita pondero-staturale (rif.: www.who.int/childgrowth).
Figura 2. Striscio periferico con numerosi acantociti.
Discussione
Il caso descritto, pur nell'eccezionale convergenza di due patologie rare, si presta ad alcune considerazioni di interesse pratico. Le transaminasi sono spesso incluse negli esami �di routine� ed � piuttosto frequente, anche nel bambino, incappare in un loro inatteso incremento. In questi casi, � difficile ignorare il dato anche se l'alterazione riguarda uno solo dei due markers (pi� probabilmente l'AST) o se � di modesta entit�. In realt�, l'innalzamento delle transaminasi � un indice sensibile di interessamento epatico, ma � di scarso aiuto nel discriminare le diverse cause del problema, come gi� ben descritto in due recenti lavori di revisione di Maggiore3,4. Il nostro caso si identifica nella cosiddetta sindrome citolitica cronica pura, con moderata (2-10 x N) e persistente elevazione delle transaminasi, senza evidente coinvolgimento delle vie biliari4. Capitolo che include un discreto numero di patologie oltre alle forme che restano �idiopatiche� al follow-up sfuggendo ad un'identificazione causale5.
L'ipofibrinogenemia che, insieme all'elevazione delle transaminasi, ha dato il via alle indagini non era espressione di un difetto globale di funzione epatica, ma di un'alterazione geneticamente determinata della sintesi del fibrinogeno ereditata, con tutta evidenza, dal padre (Box 1)6. L'analisi genetica ha consentito di identificare una rara mutazione del gene FGG (cromosoma 4) che codifica per un proteina (fibrinogeno Aguadilla) recentemente descritta e che � in grado di dare danno epatico per deposizione di fibrinogeno all'interno del reticolo endoplasmatico degli epatociti7-10. Il meccanismo sarebbe simile a quello che porta, nei difetti congeniti di α-1 antitripsina, all'accumulo della proteina anomala e al conseguente danno epatico. I rischi di sanguinamento spontaneo sono modesti, essendo i livelli stabilmente >50 mg/dl, soglia di sicurezza raccomandata anche in caso di procedure invasive o chirurgiche11,12. Pi� concreto sembra, invece, il rischio di un danno epatico evolutivo, gi� noto in pazienti adulti, ma segnalato anche in et� pediatrica7,9,10,13.
Difetti congeniti del fibrinogeno (FI) Si distinguono sulla base delle concentrazioni plasmatiche in: 1) difetti quantitativi o di tipo I (ipofibrinogenemia e afibrinogenemia) caratterizzati da ridotti livelli o assenza completa di FI immunoreattivo e 2) difetti qualitativi o di tipo II (disfibrinogenemia e ipo-disfibrinogenemia) con livelli normali o ridotti di FI associati ad una sua ridotta attivit� funzionale. Sono disordini legati a mutazioni all'interno dei 3 geni (FGA, FGB e FGG) situati sul cromosoma 4q28-30 che codificano le 3 catene del FI (Aα, Bβ e γ). L'afibrinogenemia (frequenza 1:1 milione) e l'ipofibrinogenemia sono espressione dello stato di omo- o eterozigote di un carattere autosomico recessivo mentre la disfibrinogenemia ha una trasmissione di tipo autosomico dominante. Sono note due mutazioni del gene FGG (Brescia e Aguadilla) in grado di determinare danno epatocitario cronico per deposizione ed infarcimento del reticolo endoplasmatico. L'afibrinogenemia si accompagna ad un marcato allungamento di PT e APTT e pu� esordire in epoca neonatale con sanguinamento spontaneo dal cordone ombelicale o dalle mucose mentre l'ipofibrinogenemia ha una minore tendenza al sanguinamento che pu� verificarsi, ad esempio, nel corso di procedure invasive. In tale occasione � opportuno mantenere le concentrazioni di FI >50 mg/dl con infusione e.v. di FI concentrato e utilizzare antifibrinolitici (ac. tranexamico o aminocaproico). |
Box 1. |
I bassi livelli di colesterolo e trigliceridi, emersi nel corso delle indagini, sono inusuali e possono essere secondari ad alcune patologie rilevanti (tumori, TBC, anemie gravi, importanti stati infiammatori o infettivi, ipertiroidismo, malassorbimento e malnutrizione gravi) o a difetti congeniti della sintesi del colesterolo o delle lipoproteine14,15. Gli accertamenti ci consentivano di escludere la prima ipotesi e anche la seconda sembrava improbabile, considerata l'assenza delle note sindromico-malformative che spesso accompagnano le alterazioni congenite della biosintesi del colesterolo. Eseguito un lipidogramma e dosate le apolipoproteine, l'abetalipoproteinemia � o meglio l'IBLF - � emersa come la diagnosi pi� probabile (Box 2). In realt�, l'ABL classica e l'IBLF omozigote sono clinicamente indistinguibili e, nell'attesa della conferma del difetto genetico (sul cromosoma 4 (gene MTP) per l'ABL, sul 2 (gene APOB) per l'IBLF) l'assetto lipidico e il dosaggio dell'apoB 100 nei genitori ci avevano fatto propendere per la seconda. Tuttavia, lo scanning di entrambi i geni non ha consentito di identificare alcuna mutazione patogenetica nota. Interessante anche l'assenza di steatorrea, a cui corrisponde un assetto vitaminico liposolubile pressoch� normale, la comparsa di una banda chilomicronica postprandiale al lipidogramma e l'assenza di depositi lipidici all'interno degli enterociti. Questo potrebbe essere compatibile con una residua sintesi intestinale ed attivit� dell'apoB 48 (o di frammento comunque funzionalmente attivo) che consente l'inclusione dei lipidi alimentari nei chilomicroni e il loro, almeno parziale, assorbimento15-17. Non c'� steatosi epatica ecograficamente evidente, cos� come non vi sono segni di coinvolgimento neurologico (atassia, neuropatia periferica) e oftalmico (retinite pigmentosa) che si manifestano, generalmente dopo la prima decade di vita. Questi ultimi sono conseguenti all'alterata composizione lipidica delle membrane cellulari e ad un progressivo processo di demielinizzazione che pu� essere, almeno in parte, contrastato dalla generosa supplementazione con vit. E18. Anche l'acantocitosi, espressione di un disturbo dei lipidi di membrana e di carenze vitaminiche, � assai evidente nello striscio periferico del bambino e in una piccola percentuale (<5%) di eritrociti nei genitori.
Abetalipoproteinemia Patologia legata a difetti in diversi loci genetici deputati alla sintesi delle apolipoproteine B (apoB). L'apoB 100 � sintetizzata nel fegato ed � essenziale per la formazione di LDL e VLDL, l'apoB 48 � sintetizzata nell'intestino e consente di veicolare i trigliceridi all'interno dei chilomicroni. In assenza delle apoB i lipidi (colesterolo e trigliceridi) tendono ad accumularsi nel fegato (deficit di apoB 100) e nell'intestino (deficit di apoB 48). Si distinguono due entit� nosologiche prevalenti: l'abetalipoproteinemia (ABL) classica e l'ipobetalipoproteinemia famigliare (IBLF). L'ABL (autosomica recessiva, frequenza <1:100.000) � legata all'assenza dell'attivit� della proteina di trasferimento microsomiale dei trigliceridi (MTP) codificata sul cromosoma 4q22-24. Gli eterozigoti sono asintomatici e hanno normali livelli di lipidi e lipoproteine plasmatici. Le manifestazioni cliniche sono gastrointestinali (malassorbimento dei grassi, scarsa crescita, ridotto assorbimento delle vitamine liposolubili, steatosi epatica), ematologiche (acantocitosi, deficit coagulazione vit. K � dipendente), neurologiche (atassia, neuropatia periferica) e oftalmiche (retinopatia pigmentosa). L'IBLF (autosomica dominante, frequenza: eterozigoti 1:3000, omozigoti 1:1 milione) � legata ad oltre 60 mutazioni diverse del gene APOB sul cromosoma 2 che determinano la produzione di apoB tronche con limitate capacit� di trasporto dei lipidi. In alcuni casi (persistenza di apoB 48) vi pu� essere comparsa postprandiale di lipoproteine plasmatiche contenenti trigliceridi. Gli omozigoti hanno manifestazioni cliniche simili ai pazienti con ABL con progressivo danno epatico, neurologico ed oftalmico. Gli eterozigoti hanno ridotti livelli di LDL e apoB e quadri clinici intermedi. La terapia di queste forme consiste nella limitazione dei lipidi nella dieta, nell'uso di grassi a media catena (MCT) e nella supplementazione con vitamine liposolubili (vit. E in particolare). |
Box 2. |
Difficile, a questo punto, stabilire una connessione tra i due difetti e ancor pi� una prognosi di lungo termine. Se, da un lato, livelli elevati di fibrinogeno, colesterolo e apoB incrementano il rischio di malattia coronarica, poco o nulla emerge nel senso di un difetto opposto19. Sintesi del fibrinogeno, apoB, metabolismo dei lipidi e degli acidi grassi sono certamente connessi a livello del reticolo endoplasmatico degli epatociti, ma a parte un gruppo famigliare i cui componenti erano alternativamente affetti da una IBLF e da un'a/ipofibrinogenemia20 la letteratura riporta un solo paziente che presentava contemporaneamente i due difetti. Il bambino descritto da Sogo e coll.10 aveva, infatti, oltre all'ipertransaminasemia, un'ipofibrinogenemia da mutazione Aguadilla e un'ipobetalipoproteinemia in assenza (come nel nostro paziente) di mutazioni note sui geni MTP e APOB. Alla biopsia epatica, il danno appariva legato all'accumulo di fibrinogeno all'interno del reticolo endoplasmatico degli epatociti, con un discreto grado di infiammazione e di fibrosi portale. Gli Autori ipotizzano che un disturbo nel funzionamento del reticolo endoplasmatico delle cellule epatiche sarebbe in grado di alterare la sintesi o l'assemblaggio dell'apoB e dei lipidi contribuendo a determinare l'ipobetalipoproteinemia. Questo potrebbe rendere ragione dell'assenza di mutazioni sui geni MTP e APOB e identificare nel solo accumulo di fibrinogeno la causa prima del danno epatocellulare. Peraltro, l'ipotesi di Sogo e coll. non sembra del tutto coerente con il nostro caso nel quale non � stata osservata alcuna anomalia nei livelli di altre proteine sintetizzate nel reticolo endoplasmatico degli epatociti (ceruloplasmina e α-1 antitripsina) e non spiega i bassi livelli di apoB nella madre di D. pur in assenza di alterazioni del fibrinogeno. Il caso di Sogo e coll. ed il nostro sono, inoltre, i due soli casi di epatopatia da accumulo di fibrinogeno nei quali sia stata segnalata una ridotta sintesi di apoB. L'estrema rarit� dell'associazione non esclude la possibilit� di una variante fenotipica legata, forse, ad una seconda mutazione genetica che renderebbe inefficace il sistema di clearance del fibrinogeno da parte del reticolo endoplasmatico in alcuni soggetti21, ma tiene anche aperta l'ipotesi di un distinto difetto genetico nella sintesi dell'apoB non ancora identificato.
Nel nostro paziente, a cinque anni di et�, non ci sono ancora segnali di rilevante compromissione del fegato e abbiamo convenuto di procrastinare una biopsia epatica che avrebbe oggi un significato forse speculativo, ma scarsa rilevanza terapeutica.
Bibliografia
Maggiore G. Approccio diagnostico al bambino con aminotransferasi elevate. Area Pediatrica 2002;3:5-23.
Giannini EG, Testa R, Savarino V. Liver enzyme alteration: a guide for clinicians. CMAJ 2005;172:367-79.
Maggiore G. L'esplorazione bioumorale del fegato: il bilancio epatico. Medico e Bambino 2009;28:649-53.
Maggiore G. Approccio clinico al bambino con enzimi epatici elevati, �quasi� vent'anni dopo� Medico e Bambino 2010;29:21-32.
Zancan L, Bettiol T, Rini A, et al. Chronic idiopathic hypertransaminasemia. Minerva Pediatr 1996; 48:209-16.
Peyvandi F, Cattaneo M, Inbal A, De Moerloose P, Spreafico M. Rare Bleeding disorders. Haemophilia 2008;14 (suppl 3):202-210.
Brennan SO, Maghzal G, Shneider BL, et al. Novel fibrinogen 375 ArgTrp mutation (fibrinogen Aguadilla) causes hepatic endoplasmic reticulum storage and hypofibrinogenemia. Hepatology 2002;36:652-8.
Vu D, Neerman-Arbez. Molecular mechanisms accounting for fibrinogen deficiency: from large deletions to intracellular retention of misfolded proteins. J Thromb Haemost 2007;5(suppl 1):125-131.
Francalanci P, Santorelli FM, Talini I, et al. Severe liver disease in early childhood due to fibrinogen storage and de novo gamma 375Arg →Trp gene mutation. J Pediatr 2006;148:396-398.
Sogo T, Nagasaka H, Komatsu H, et al. Fibrinogen storage disease caused by Aguadilla mutation presenting with hypobeta-lipoproteinemia and considerable liver disease. J Pediatr Gastroenterol Nutr 2009;49:133-36.
Mannuccio PM, Duga S, Peyvandi F. recessively inherited coagulation disorders. Blood 2004;104:1243-1252.
Bolton-Maggs PHB, Perry DJ, Chalmers EA, et al. The rare coagulation disorders � review with guidelines for management from the United Kingdom Haemophilia Centre Doctors' Organization. Haemophilia 2004;10:593-628.
Rubbia-Brandt L, Neerman-Arbez M, Rougemont A-L, et al. Fibrinogen gamma375 Arg Trp mutation (fibrinogen Aguadilla) causes hereditary Hypofibrinogenemia, hepatic endoplasmic reticulum storage disease and cirrhosis. Am J Surg Pathol 2006;30:906-11.
Waterham HR. Inherited disorders of cholesterol biosynthesis. Clin Genet 2002;61:393-403.
Burnett JR, Hooper A. Commom and rare gene variants affecting plasma LDL cholesterol. Clin Biochem Rev 2008;29:11-25.
Hooper AJ, Robertson K, Barrett PHR, et al. Postprandial lipoprotein metabolism in familial hypobelipoproteinemia. J Clin Endocrinol Metab 2007;92:1474-1478.
Pautler D, Easley D, Pohl JF. Abetalipoproteinemia. J Pediatr Gastroenterol Nutr 2008;46:355.
Zamel R, Khan R, pollex R, Hegele R. Abetalipoproteinemia: two case reports and literature review. Orphanet J Rare Dis 2008;3:19-26.
Redman CM, Xia H. Fibrinogen biosynthesis. Assembly, intracellular degradation, and association with lipid synthesis and secretion. Ann N Y Acad Sci 2001;936:480-95.
Lane DM, McConathy WJ, Comp PC, Gilcher RO. Afibrinogenemia and hypobetalipoproteinemia in a kindred. Arch Intern Med 1991;151:800-804.
Kruse KB, Dear A, Kaltenbrun ER, et al. Mutant fibrinogen cleared from the endoplasmic reticulum via endoplasmic reticulum-associated protein degradation and autophagy. An explanation for liver disease. Am J Pathol 2006;168:1299-308.
Ringraziamenti
Le indagini sul gene MTP e APOB sono state eseguite nel Dipartimento di Scienze Biomediche � Sezione di Patologia Generale dell'Universit� di Modena e Reggio Emilia (prof. Patrizia Tarugi). Le indagini sul gene FGG sono state eseguite nel Dipartimento di Biologia e Genetica e Genetica per le Scienze Mediche dell'Universit� degli Studi di Milano (prof. Stefano Duga). Grazie alla dott.ssa Stella Schena per avere condiviso con noi la storia di D., al dott. Pierluigi Marradi per la consulenza ematologica, al prof. Giuseppe Lippi e alla dott.ssa Antonella Bassi per l'interpretazione del lipidogramma. Il caso � stato presentato a �Casi indimenticabili in pediatria ambulatoriale�, Vicenza, 6 Febbraio 2009.
